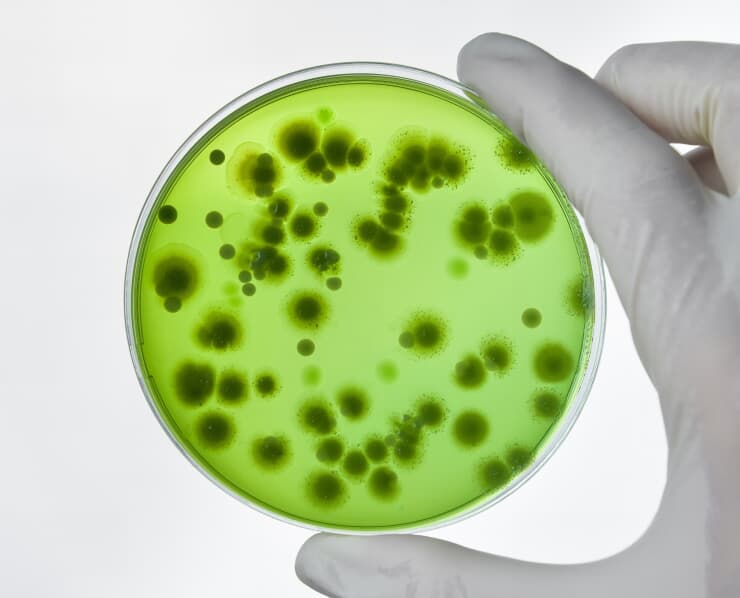

Caring for your health needs
We provide & deliver skilled care teams
Elementra strives to make healthcare more accessible, providing expert medical services that help individuals live healthier lives every day. Our team’s focus on care and progress means each service is tailored.

General consultation

Pediatric care

Diagnostic imaging
Laboratory testing
Precise laboratory tests designed to detect, monitor, and help prevent diseases

Research & innovation

Health analytics
Transforming your health journey
We deliver & provide trusted care
Elementra is committed to delivering exceptional healthcare, providing advanced medical services that support our patients’ well-being every day. Our expert team ensures each treatment is personal and effective.
Exceptional healthcare
Our hospital delivers expert care for every patient.
Specialty care options
We offer advanced treatments to support your health.
Modern medical care
Our team provides diagnostics, therapy, and support.
Essential services
We support patients with skilled care and new methods.
Care that matters most
We redefine patient wellness
01
Medical services
Our hospital provides expert care across specialties, from diagnostics to advanced treatments. We focus on your comfort and health at each step.
02
Specialty clinics
Elementra offers tailored specialty care, from cardiology to oncology. Our experts create treatment plans for every patient need.
